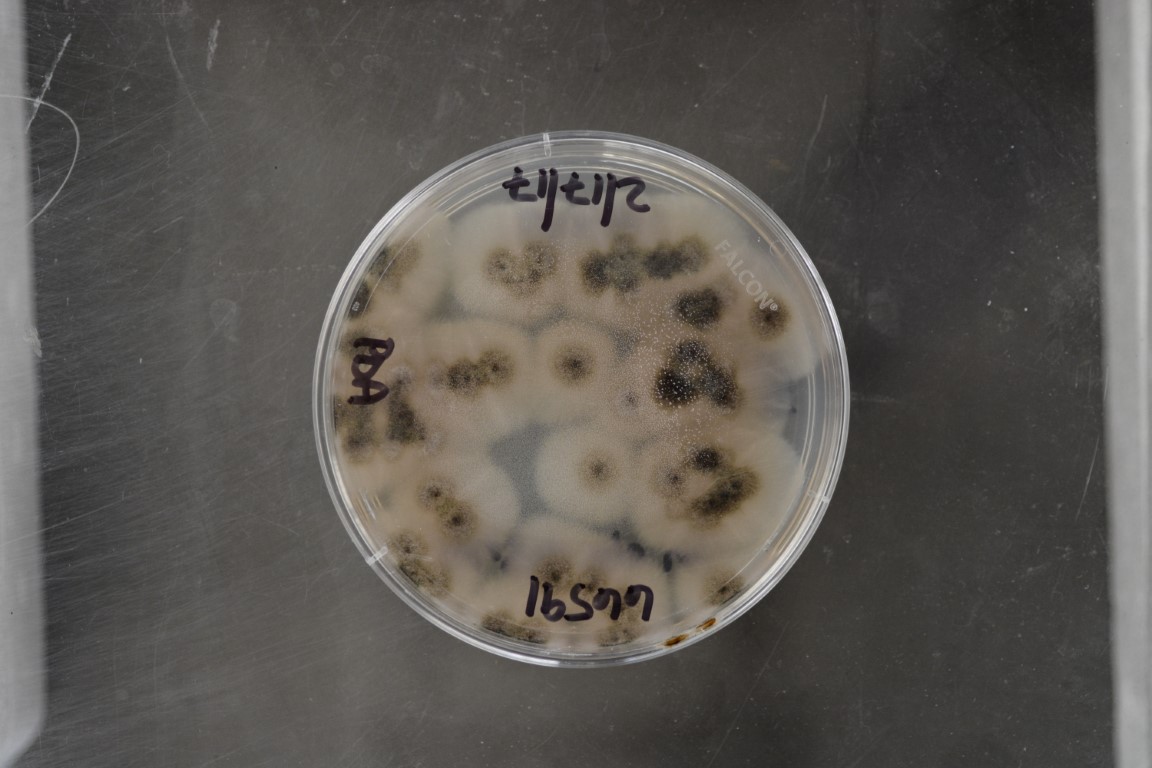

Stachybotrys charlesii
NRRL 66591
Source:Charles L.Biles,Biology Department,East Central University,Ada,Oklahoma 74820
Isolated from(substrate):cloth from a chair
Substrate location:chair subjected to high humidity,Ada,OK,USA
Genetic info:GenBank accession#KY454472
Growth media:Potato Dextrose Agar(number 3)
Optimum growth temperature:25C
Strain images:
NRRL_66591_3.JPG

NRRL66591